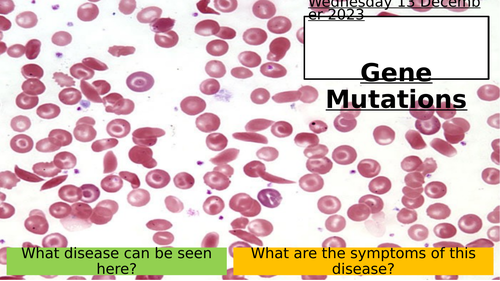
pptx, 3.01 MB

This resource guides a-level biologists through gene mutations. Stretch, challenge and lateral thinking questions are embedded throughout. This is a resource been made to be picked up and used by any teacher.
AQA Biology
Get this resource as part of a bundle and save up to 12%
A bundle is a package of resources grouped together to teach a particular topic, or a series of lessons, in one place.
AQA Gene Expression - BUNDLE
This bundle covers topic 15 in AQA ALevel Biology and includes the following resources: 20.1 Gene Mutations 20.2 Stem Cells and Totipotency 20.3 Regulation of Transcription and Translation 20.4 Epigenetics and Control of Gene Expression 20.5 Gene Expression & Cancer 20.6 Genome Projects
AQA Gene Expression - BUNDLE
This bundle includes 6 well thought out and easy to use lessons on: 20.1- Gene Mutations 20.2 - Stem Cells & Totipotency 20.3 - Regulation of Transcription & Translation 20.4 - Epigenetics & Control of Gene Expression 20.5 - Gene Expression & Cancer 20.6 - Genome Projects AQA Biology
AQA Section 8 - The Control of Gene Expression - BUNDLE
This resource bundle contains all of the lessons you need to teach section 8 - The Control of Gene Expression, AQA A Level Biology . This includes: 20.1 - Gene Mutations 20.2 - Stem Cells & Totipotency 20.3 - Regulation o Transcirption & Translation 20.4 - Epigenetic Control of Gene Expression 20.5 - Gene Expression & Cancer 20.6 - Genome Projects 21.1 - Producing DNA Fragments 21.2 - In Vivo Cloning 21.3 - In Vitro Cloning 21.4 - Locating Genes, Genetic Screening and Counselling 21.5 - Genetic Fingerprinting
Something went wrong, please try again later.
This resource hasn't been reviewed yet
To ensure quality for our reviews, only customers who have purchased this resource can review it
Report this resourceto let us know if it violates our terms and conditions.
Our customer service team will review your report and will be in touch.
